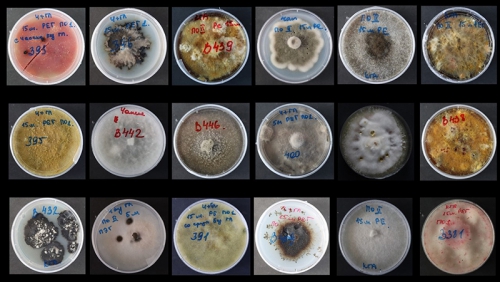
ВНИМАНИЕ! КОНКУРС! - 1 слайд

ВНИМАНИЕ! КОНКУРС!
Как вы помните, на дне открытия фотовыставки "Невидимый мир пластисферы озера Байкал" все присутствующие получили в подарок набор для самостоятельного выращивания микроорганизмов. Пришло время показать всем, что из этого получилось. Победители будут определены путем зрительского голосования.
Итак, условия:
1. Нужно сфотографировать чашку с уже наверняка подросшими микроорганизмами (скорее всего, это что-то типа плесени).
2. Придумать название фотографии (включите свою фантазию на максимум).
3. Отправить фото с подписью нам до 28 июля.
4. Принять участие в голосовании (победители будут определены по количеству лайков и комментариев).
5. Получить приз (при условии присуждения одного из 3 мест)